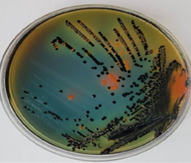

Opis

|
Kierownik Pracowni
prof. dr hab. n. med. Rafał L. Górny
Publikacje
- Górny R.L., Gołofit-Szymczak M.: Prawne wymogi kontroli szkodliwych czynników biologicznych w świetle zmian legislacyjnych w latach 2000-2020, Bezpieczeństwo Pracy. Nauka i Praktyka, 2022, 7(610), s. 12-20
- Ławniczek-Wałczyk A., Górny R. L.: Biofilm jako zagrożenie w zakładach produkcji i przetwarzania żywności, Bezpieczeństwo Pracy. Nauka i Praktyka, 2022, 3(606), s. 10-15
- Stobnicka-Kupiec A., Górny R. L. : Wirusy enteropatogenne w środowisku pracy pracowników oczyszczalni ścieków, Bezpieczeństwo Pracy. Nauka i Praktyka, 2021, 5(596), s. 14-18
- Ławniczek-Wałczyk A. : Produkcja mięsa i związane z nią zawodowe narażenie na szkodliwe czynniki biologiczne, Bezpieczeństwo Pracy. Nauka i Praktyka, 2021, 6(597), s. 19-23
- Gołofit-Szymczak M., Górny R. L.: Szczepienia ochronne w Polsce, Bezpieczeństwo Pracy. Nauka i Praktyka, 2021, 7(598), s. 18-21
- Górny R.L., Gołofit-Szymczak M., Wójcik-Fatla A., Cyprowski M., Stobnicka-Kupiec A., Ławniczek-Wałczyk A.: Microbial contamination of money sorting facilities, Annals of Agricultural and Environmental Medicine, 2021, 28(1), s. 61-71
- Cyprowski M., Ławniczek-Wałczyk A., Stobnicka-Kupiec A., Górny R.L.: Occupational exposure to anaerobic bacteria in a waste sorting plant, Journal of the Air & Waste Management Association, 2021, 71(10), s. 1292-1302
- Gołofit-Szymczak M.: Szkodliwe czynniki biologiczne w samochodowych instalacjach klimatyzacyjnych, Bezpieczeństwo Pracy. Nauka i Praktyka, 2020, 3(582), s. 9-11
- Górny R.L.: Microbial aerosols: sources, properties, health effects, exposure assessment – a review, KONA Powder and Particle Journal, 2020, Vol. 37, 2020005, s. 64-84
- Górny R., Frączek K., Ropek D.R.: Size distribution of microbial aerosols in overground and subterranean treatment chambers at health resorts, Journal of Environmental Health Science and Engineering, 2020, 18, s. 1437-1450
- Stobnicka-Kupiec A.,: Bakterie enteropatogenne w środowisku pracy oczyszczalni ścieków, Bezpieczeństwo Pracy. Nauka i Praktyka, 2020, 4(583), s. 27-31
- Stobnicka-Kupiec A., Gołofit-Szymczak M., Górny R.L., Cyprowski M.: Prevalence of bovine leukemia virus (BLV) and bovine adenovirus (BAdV) genomes among air and surface samples in dairy production, Journal of Occupational and Environmental Hygiene, 2020, 17(6), s. 312-323
- Cyprowski M., Stobnicka-Kupiec A., Górny R.L., M. Gołofit-Szymczak , Ptak-Chmielewska A., Ławniczek-Wałczyk A.: Across-shift changes in upper airways after exposure to bacterial cell wall components, Annals of Agricultural and Environmental Medicine, 2020, 26, s. 236-241
- Ławniczek-Wałczyk A., Orysiak J., Stobnicka-Kupiec A.: Wspomaganie dietą układu odpornościowego w walce z infekcją, Bezpieczeństwo Pracy. Nauka i Praktyka, 2020, 6(585) , s. 12-16
- Górny R.L., Gołofit-Szymczak M.: Adverse health outcomes among workers of wood pellet production facilities, Annals of Agricultural and Environmental Medicine, 2020, online
- Gołofit-Szymczak M., Górny R.L.: Postępowanie z odpadami medycznymi, Bezpieczeństwo Pracy. Nauka i Praktyka, 2020, 8(587), s. 16-19
- Stobnicka-Kupiec A., Górny R.L., Gołofit-Szymczak M., Ławniczek-Wałczyk A., Cyprowski M.: Koronawirusy – niewidzialne zagrożenie o globalnym zasięgu, Podstawy i Metody Oceny Środowiska Pracy, 2020, 4(106), s. 5-35
- Ławniczek-Wałczyk A.: Przystosowanie stanowiska pracy i ochrona zdrowia pracowników w czasie epidemii, Bezpieczeństwo Pracy. Nauka i Praktyka, 2020, 7(586), s. 4-7
- Górny R.L., Gołofit-Szymczak M.: Adverse health outcomes among workers of wood pellet production facilities, Annals of Agricultural and Environmental Medicine, 2020, 27(1), s. 154-159
- Górny R.L.: Microbiological Corrosion of Buildings. A Guide to Detection, Health Hazards, and Mitigation, CRC Press / Taylor & Francis Group, 2020
- Gołofit-Szymczak M., Górny R.L., Stobnicka-Kupiec A.: Impact of air-conditioning system disinfection on microbial contamination of passenger cars, Air Quality, Atmosphere & Health, 2019, 12, s. 1127-1138
- Ławniczek-Wałczyk A., Górny R.L.: Transport of microbial components in coarse and fine particle fractions in office buildings, Annual Set The Environment Protection (Rocznik Ochrona Środowiska), 2019, 21, s. 1099-1115
- Cyprowski M., Ławniczek-Wałczyk A., Gołofit-Szymczak M., Frączek K., Kozdrój J., Górny R.L.: Bacterial aerosols in a municipal landfill environment, Science of the Total Environment, 2019, 660, s. 288-296
- Górny R.L., Gołofit-Szymczak M., Cyprowski M., Stobnicka-Kupiec A: Nasal lavage as analytical tool in assessment of exposure to particulate and microbial aerosols in wood pellet production facilities, Science of the Total Environment, 2019, 697, 134018
- Stobnicka-Kupiec A., Gołofit-Szymczak M., Górny R.L.: Microbial contamination level and microbial diversity of occupational environment in commercial and traditional dairy plants, Annals of Agricultural and Environmental Medicine, 2019, vol. 26, 4, s. 555-565.
- Gołofit-Szymczak M, Górny R. L.: Narażenie pracowników opieki zdrowotnej na patogeny krwiopochodne, Bezpieczeństwo Pracy. Nauka i Praktyka, 2019, 1(568), s. 15-18
- Ławniczek-Wałczyk A., Górny R.L.: Patogeny oporne na antybiotyki w środowisku pracy , Bezpieczeństwo Pracy. Nauka i Praktyka, 2019, 12(579), s. 9-13
- Gołofit-Szymczak M., Górny R.L., Stobnicka-Kupiec A.: Microbial air quality in municipal buses before and after disinfection of their air-conditioning systems, Journal of Ecological Engineering, 2019, vol. 20, 10, s. 189-194
- Cyprowski M.: Szkodliwe czynniki biologiczne w zakładach termicznego unieszkodliwiania odpadów komunalnych, Medycyna pracy, 2019, 70(1), s. 99–105
Pracownia Zagrożeń Biologicznych
oferta pomiarów, ekspertyz, badań
Ekspertyzy w zakresie oceny narażenia na szkodliwe czynniki biologiczne w środowisku pracy i w środowisku pozazawodowym, korozji biologicznej i działań remediacyjnych w budynkach oraz oceny stanu instalacji klimatyzacyjnych i wentylacyjnych pod kątem ich zanieczyszczenia aerozolami biologicznymi.
Badania mikrobiologiczne powietrza
Próbki powietrza pobierane są zgodnie z Polską Normą PN-EN 13098:2020-01 „Narażenie na stanowiskach pracy - Pomiar mikroorganizmów i produktów pochodzenia drobnoustrojowego zawieszonych w powietrzu - Wymagania ogólne”.
Zakres analiz mikrobiologicznych obejmuje:
- oznaczenie ogólnej liczby bakterii (w tym promieniowców i bakterii Gram-ujemnych),
- oznaczenie liczby grzybów (grzyby pleśniowe i drożdżoidalne),
- pełną identyfikację jakościową wyizolowanych drobnoustrojów do poziomu rodzaju lub gatunku.
Na indywidualne zlecenie Zamawiającego istnieje możliwość rozszerzenia badań o oznaczenie bakterii beztlenowych (wycena indywidualna).
Wyniki badań są interpretowane w oparciu o polskie (opracowane przez Zespół Ekspertów ds. Czynników Biologicznych Międzyresortowej Komisji ds. Najwyższych Dopuszczalnych Stężeń i Natężeń Czynników Szkodliwych dla Zdrowia w Środowisku Pracy) i światowe propozycje wartości dopuszczalnych stężeń szkodliwych czynników biologicznych. Zidentyfikowane drobnoustroje są klasyfikowane do grup zagrożenia zgodnie z rozporządzeniem Ministra Zdrowia w sprawie szkodliwych czynników biologicznych dla zdrowia w środowisku pracy oraz ochrony zdrowia pracowników zawodowo narażonych na te czynniki, DzU z 2020 r., poz. 2234).
Inne badania laboratoryjne i usługi
- badanie masek medycznych na zgodność z polską normą PN-EN 14683:2025-06 Maski medyczne - Wymagania i metody badań, w zakresie skuteczności filtracji szczepów bakterii, czystości mikrobiologicznej i oporów oddychania;
- badanie czystości mikrobiologicznej powierzchni i materiałów (np. dokumenty, blaty robocze, ściany, podłogi, urządzenia, filtry itp.) metodą wymazu, metodą odciskową lub wymywania;
- oznaczenia stężeń endotoksyn bakteryjnych, m.in. w powietrzu oraz w cieczach chłodzących;
- badanie czystości rąk pracowników;
- szkolenia z zakresu oceny narażenia zawodowego na szkodliwe czynniki biologiczne na różnych stanowiskach pracy;
- analiza ryzyka zawodowego związanego z narażeniem na czynniki biologiczne, wraz z rekomendacjami działań profilaktycznych i ochronnych.
Koszty
Koszty badań ustalane są indywidualnie, w zależności od rodzaju oraz liczby analizowanych próbek.
Pracownicy
| Kierownik | Numer telefonu | |
|---|---|---|
| prof. dr hab. n. med. Rafał Górny | (22) 623-46-77 | ragor@ciop.pl |
| Numer telefonu | ||
|---|---|---|
| dr hab. n. med. Marcin Cyprowski | (22) 623-46-92 | macyp@ciop.pl |
| dr Małgorzata Gołofit-Szymczak | (22) 623-46-82 | magol@ciop.pl |
| inż. Bartłomiej Wróbel | (22) 623-32-17 | bawro@ciop.pl |
| dr Anna Ławniczek-Wałczyk | (22) 623-46-92 | anlaw@ciop.pl |
Lista Projektów
-
Ocena występowania grzybów o właściwościach zakaźnych i toksycznych na włókninach filtracyjnych pochodzących z układów wentylacyjnych środków transportu
Kierownik projektu: dr Małgorzata Gołofit-Szymczak
-
Badanie narażenia pracowników konfekcjonowania i dystrybucji środków płatniczych oraz populacji generalnej korzystającej z bankomatów na szkodliwe czynniki mikrobiologiczne
Kierownik projektu: prof. dr hab. n. med. Rafał L. Górny
-
Ocena właściwości toksycznych i alergizujących pleśni z rodzaju Aspergillus w środowisku pracy archiwów i bibliotek
Kierownik projektu: dr hab. n. med. Marcin Cyprowski
|
Pracownia Zagrożeń Biologicznych - Interesujące odnośniki |
